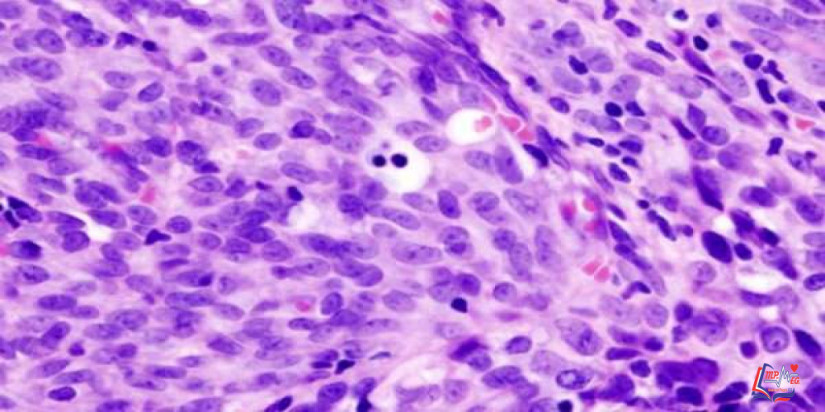
الساركوما الوعائية Angiosarcoma

الساركوما الوعائية Angiosarcoma
الساركوما الوعائية هي نوع نادر من السرطان يُصيب بطانة الأوعية الدموية و الليمفاوية، وتمثل الأوعية الليمفاوية جزء من الجهاز المناعي، يجمع البكتيريا والفيروسات والمواد الضارة، ثم تقوم بإخراجها من الجسم.
وعلى الرغم أن هذا السرطان قد ينمو في أي منطقة من الجسم، إلا أنه يظهر غالباً في جلد الرأس و الرقبة، و نادراً ما يظهر في أجزاء أخرى مثل منطقة الصدر أو الأنسجة الداخلية كالقلب و الكبد، كما أن هذا السرطان قد يظهر في أماكن قد تعرضت مسبقاً للإشعاع.
أعراض الساركوما الوعائية
أعراض هذا المرض تختلف على حسب مكان وجوده.
الساركوما الوعائية في الجلد
في أغلب الأحيان يظهر هذا السرطان على جلد الرأس والرقبة، خصوصاً على فروة الرأس. وأعراض هذا النوع من السرطان تتضمن:
- ارتفاع منطقة الجلد المصابة ويكون لونها بنفسجياً، وتشبه الكدمة.
- منطقة من الجلد مصابة تشبه الكدمة وتنمو مع مرور الوقت.
- منطقة من الجلد مصابة تنزف إذا تم الإحتكاك بها.
- ورم في الجلد حول المنطقة المصابة.
الساركوما الوعائية في الأعضاء الداخلية
عندما يصيب هذا السرطان الأعضاء الداخلية كالكبد والقلب، غالباً ما يُسبب الألم. والأعراض الأخرى تعتمد على مكان وجود السرطان.
ضرورة استشارة الطبيب
قم بحجز موعد مع طبيبك إذا كنت تعاني من أعراض مستمرة وتثير قلقك.
أسباب الساركوما الوعائية
ليس من الواضح أسباب حدوث الساركوما الوعائية، ولكن تعَرف الأطباء على بعض عوامل الخطورة التي تُزيد نسبة حدوث المرض. ويعلم الأطباء أن شيئاً ما يحدث للخلايا التي تبطن الأوعية الدموية والليمفاوية، مما يؤدي إلى حدوث خلل في الكود الجيني. وهذا الخلل يأمر الخلية بالنمو بسرعة، مما يؤدي إلى زيادة عدد إنتاج الخلايا الغير طبيعية. وتلك الخلايا الغير طبيعية تستمر في البقاء عندما تموت بقية الخلايا.
والنتيجة هي تراكم الخلايا الغير طبيعية التي تنمو في الوعاء الدموي أو الليمفاوي المصاب، ومع الوقت، يمكن أن تنفصل تلك الخلايا وتهاجر إلى مناطق اخرى من الجسم.
عوامل خطورة الساركوم الوعائية
العوامل التي تزيد احتمالية الإصابة بالساركوما الوعائية تشمل ما يلي:
- العلاج بالإشعاع. العلاج الإشعاعي لمداواة السرطان أو أمراض أخرى يزيد احتمالية الإصابة بالساركوما الوعائية. والإصابة بهذا السرطان نتيجة الإشعاع العلاجي نادر الحدوث، وقد يظهر بعد 5 أو 10 سنوات من العلاج.
- تورم بسبب تلف في الأوعية الليمفاوية. وهذا التورم هو بسبب تجمع السائل الليمفاوي نتيجة انسداد أو تلف الجهاز الليمفاوي. ومن أسباب هذا المرض هو إزالة الغدد الليمفاوية أثناء عملية جراحية، غالباً لاستئصال ورم. وهذا الورم من الممكن أن يحدث أيضاً بسبب الإصابة بعدوى ومشاكل صحية إخرى.
- الكيماويات. تم ربط الساركوما الوعائية في الكبد بالتعرض لعدة مواد كيميائية، منها كلوريد الفينيل والزرنيخ.
تشخيص الساركوما الوعائية
الاختبارات والطرق المستخدمة لتشخيص الساركوما الوعائية تتضمن ما يلي:
- الفحص البدني. سيفحصك طبيبك بدقة ليفهم حالتك.
- أخذ عينة من الجلد للفحص. سيأخذ الطبيب عينة من الجلد المصاب للفحص المعملي. وتحليل المعمل سيكتشف خلايا السرطان وسيحدد صفات تلك الخلايا ليساعدك في اختيار طريقة العلاج.
- اختبارات تصويرية. تلك الاختبارات تساعد طبيبك على تحديد إذا كان السرطان انتشر و إلى أي مدى. تلك الاختبارات تتضمن الأشعة المقطعية، الرنين المغناطيسي والتصوير المقطعي البوزيتروني (PET). ونوع الاختبار الذي تحتاج إليه يتوقف على حالتك.
علاج الساركوما الوعائية
يعتمد العلاج الأفضل لهذا النوع من السرطان على مكان تواجده، حجمه وإذا ما كان انتشر إلى أنحاء أخرى في الجسم. وبعض طرق العلاج تشمل:
- الجراحة. هدف الجراحة هو استئصال الورم بالكامل، حيث يقوم الجراح بإزالة الورم وبعضاً من النسيج الطبيعي حوله. وفي بعض الحالات الجراحة ليست خيار علاجي، مثل إذا كان السرطان كبير جداً أو إذا كان انتشر لمناطق أخرى في الجسم.
- العلاج بالإشعاع. العلاج الإشعاعي يستخدم أشعة ذات طاقة عالية، مثل الأشعة السينية و البروتونات، لقتل الخلايا السرطانية. والعلاج الإشعاعي أحياناً يُستخدم بعد الجراحة لقتل أي خلايا سرطانية متبقية. وقد يكون خياراَ إذا كنت لا تستطيع اجراء عملية جراحية.
- العلاج الكيميائي. العلاج الكيميائي هو علاج يستخدم أدوية أو كيماويات لقتل خلايا السرطان. وهذا النوع من العلاج من الممكن استخدامه إذا كانت الخلايا السرطانية انتشرت في الجسم. ومن الممكن استخدام العلاج الكيميائي والإشعاعي معاً إذا كان ليس باستطاعتك إجراء عملية جراحية.
الاستعداد لموعد مع الطبيب
غالباً ستزور طبيبك العام أولاً، وإذا اشتبه طبيبك في الساركوما الوعائية، فسيتم تحويلك إلى طبيب يختص بالأمراض الجلدية أو طبيب مختص بالأورام. وإليك بعض المعلومات التي سوف تساعدك للإستعداد لموعدك الطبي.
ماذا يمكنك فعله
- كن على دراية بالممنوعات قبل موعدك، فعندما تحجز موعد مع الطبيب، اسأل الطبيب إذا كنت محتاج لأي تجهيزات قبل الزيارة، كتغيير شيء في نظامك الغذائي.
- اكتب أعراضك، وأضف أي عرض، حتى لو كنت تعتقد أنها ليست لها علاقة بأعراضك الحالية.
- اكتب أي معلومات شخصية أساسية، وذلك يتضمن أي ضغوطات أو تغيرات جديدة في حياتك.
- اكتب كل الأدوية التي تأخذها، وأضف الفيتامينات والمكملات، وأذكر الجرعات.
- اطلب من أقاربك أو أحد أصدقائك المجيء معك إلى الطبيب، لأنهم سوف يتذكرون ما أوصى به الطبيب.
- اكتب كل الأسئلة التي تريد سؤالها لطبيبك.
وتحضير قائمة بالأسئلة يساعدك على استغلال وقتك مع الطبيب بطريقة جيدة. ورتب الأسئلة من الأهم إلى الأقل أهمية. وبالنسبة للساركومة الوعائية، إليك بعض الأسئلة الأساسية:
- ما مدى تقدم هذا السرطان؟
- هل انتشر السرطان إلى مناطق أخرى من جسمي؟
- ما هي طرق العلاج المتوفرة؟ وبأي منها تنصح؟
- ما هي مزايا ومخاطر كل طريقة من طرق العلاج؟
- ما هي أفضل طريقة لعلاج هذه المشكلة، إذا كنت أعاني من مشاكل صحية أخرى؟
- هل عيجب أن أمتنع عن تأدية عملي و نشاطاتي أثناء العلاج؟
- هل يجب أم استشير طبيب ثاني لأخذ رأي آخر؟
- هل علي زيارة طبيب مختص بالأورام؟
- هل علي اتخاذ قرار في طريقة العلاج بسرعة؟ هل يمكنني أخذ بعض الوقت لأفكر في الخيارات المتاحة؟
- هل لديك أي نشرات أو مطبوعات ورقية بها معلومات عن المرض يمكنني أخذها؟ وما هي المواقع الالكترونية التي تنصحني بزيارتها للقراءة عن المرض؟
ولا تتردد في سؤال الطبيب أي أسئلة أخرى.
ما هو المتوقع من طبيبك المعالج
سوف يسألك الطبيب بعض الأسئلة، وكونك مستعد للإجابة عن تلك الأسئلة، يجعل لديك الوقت الإضافي للتطرق إلى مواضيع تريد التحدث فيها بصورة أكثر عمقاً. وبعض الأسئلة التي سيسأل عنها طبيبك تتضمن:
- متى كانت أول مرة تعرضت لهذه الأعراض؟
- هل تلك الأعراض مستمرة أم متقطعة؟
- ما هي شدة تلك الأعراض؟
- هل هناك أي شيء يُحسن المشكلة؟
- هل هناك أي شيء يزيد المشكلة سوءً؟ ما هي؟
- هل تم تشخيصك بأي مرض آخر؟
- هل تأخذ أي أدوية حالياً، بما في ذلك، الفيتامينات والمكملات؟